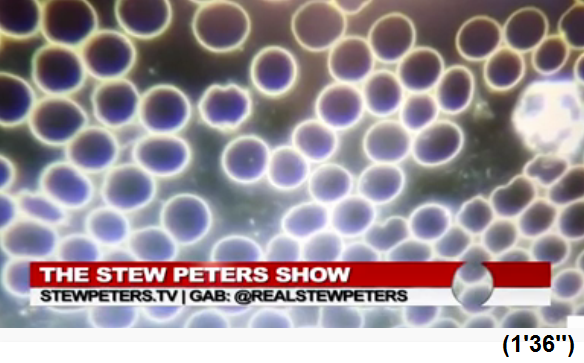

========
Auch in den "USA"
22.5.2021: Gen-Geimpfte können kein Blut spenden:
Amerikanisches Rotes Kreuz: Geimpfte Menschen können
kein Blut spenden, weil der Impfstoff ihre natürlichen
Antikörper vollständig zerstört ...
https://t.me/gartenbaucenter17/28844
========
Gen-Geimpfte
24.5.2021: Gen-Geimpfte dürfen KEIN Blut spenden - das
Blut ist Gen-VERSEUCHT!
ROTES KREUZ: GEIMPFTES BLUT WERTLOS - NICHT FÜR
BLUTPLASMA GEEIGNET - NEW 4 AT, USA, 05.2021
Video-Link: https://t.me/oliverjanich/61739
Video-Link auf Bitchute: https://www.bitchute.com/video/iSt216MQ0UXY/
<Ein vollkommen unerklärliches Verhalten, würde es sich
um einen 'normalen Impfstoff' handeln. Das Blut Geimpfter
ist nicht nur nicht für die Behandlung von
Covid-19-Patienten geeignet. Es ist laut Rotem Kreuz sogar
schädlich.
"....Das Rote Kreuz sagt, dass niemand, der eine
Covid-19-Impfung erhalten hat, Blutplasma spenden kann, um
anderen Covid-19-Patienten in Krankenhäusern zu helfen.
Dieses Plasma wird aus den Antikörpern von Menschen
erzeugt, die das Virus überstanden haben. Aber diese
Antikörper werden vom Impfstoff ausgelöscht und machen das
Plasma unbrauchbar und schädlich für Covid-19-Patienten."
Das hört sich nicht nach einer brauchbaren Waffe gegen das
Sars-Cov-2-Virus an. Man vermutet unweigerlich, dass eher
das Gegenteil der Fall ist. Wohl nicht ganz grundlos.>
Einbetten: <div align="center"><iframe
scrolling="no" style="border: none;" src="https://www.bitchute.com/embed/iSt216MQ0UXY//"
width="640" frameborder="0"
height="360"></iframe></div>
========
Japan 31.5.2021: Das Blut
von Gen-Geimpften ist nicht sicher - KEIN Blutspenden
möglich:
Japanisches Rotes Kreuz verweigert Blutspenden von
Menschen, die gegen COVID-19 geimpft“ sind‼️
https://connectiv.events/japanisches-rotes-kreuz-verweigert-blutspenden-von-menschen-die-gegen-covid-19-geimpft-sind/
<Das Japanische Rote Kreuz weigert sich nun,
Blutspenden von Menschen anzunehmen, die den Impfstoff
gegen das Wuhan-Coronavirus (COVID-19) erhalten haben. Auf
der Website des Japanischen Roten Kreuzes heißt es, dass
Personen, die gegen COVID-19 geimpft wurden, „bis auf
Weiteres kein Blut spenden dürfen“. Auf derselben Seite
werden potenzielle Blutspender gewarnt, dass sie ihr Blut
für eine bestimmte Zeit nicht spenden können, nachdem sie
verschiedene Impfungen erhalten haben.>
========
Blutspenden Winterthur 9.7.2021: Auch
Gengeimpfte dürfen spenden - Kontrollorgane wissen
NICHTS!
Mara, [09.07.21 08:39]
https://t.me/Impfschaden_Corona_Schweiz/14430
Eine neue Meldung:
Hallo Mara
Meine Kollegin arbeitet in einem Blutspendezentrum in
Winterthur. Und sie nehmen ohne Probleme auch Leute,
die bereits gegen Covid geimpft wurden.
> Ich finde das unverantwortlich, was können wir
dagegen tun?
> Sie hat Angst, das dort anzusprechen, weil sie
den Job nicht verlieren möchte und die Einzige ist,
die so aufgeklärt ist. Soviel ich weiss, muss sie auch
trotz ärztlichem Attest eine Maske tragen.
Wir bitten um Ihre Unterstützung.
========
Blutspenden 12.7.2021: WAS passiert, wenn
GENgeimpftes Blut als Blutspende bei UNgeimpften
verwendet wird?
Mara, [12.07.21 10:35]
https://t.me/Impfschaden_Corona_Schweiz/14623
Eine neue Meldung:
Liebe Mara, Danke Danke Danke wiedermal für
deinen/euren unglaublich wertvollen Einsatz🙏🏻
Es ist unfassbar, dass Blutspenden bei geimpften hier
in der CH gar kein Thema ist. Was passiert, wenn eine
Person die nicht geimpft ist zb.einen Autounfall hat,
eine Bluttransfusion braucht und Blut von einer
geimpften Person erhält?
========
15.7.2021:
Medizinisches: Blutbild von GENgeimpften:
Video 15.7.2021: Bombshell discovery -
what are shots doing to your blood?
https://rumble.com/vjw5kq-breaking-discovery-what-covid-injections-do-to-your-blood-doctor-releases-h.html
Das Video ist auch auf Bitchute:
Video
15.7.2021: Vergleich Blutbild
gesund-GENgeimpft - comparison blood
healthy-vaccinated (11'51'')
15.7.2021: Vergleich Blutbild
gesund-GENgeimpft - comparison blood
healthy-vaccinated (11'51'')
https://www.bitchute.com/video/DW5aZQCK8YBc/
- Bitchute-Kanal: NatMed-etc. -
hochgeladen am 27.9.2021
Code zum Einbetten:
<div
align="center"><iframe scrolling="no"
style="border: none;" src="https://www.bitchute.com/embed/DW5aZQCK8YBc//"
width="640" frameborder="0"
height="360"></iframe></div>
Beim gesunden Blut (links) sind die Blutzellen wie
Billardkugeln und der Sauerstofftransport ist 100%,
die Person ist sportlich fit. Link:
https://www.bitchute.com/video/DW5aZQCK8YBc/ - Die
Blutzellen der GENgeimpften sind zerknittert,
verhaken sich, provozieren Blutgerinnsel+Thrombosen.
UND: Sauerstofftransport ist kaum noch möglich,
Dauermüdigkeit, weil alle Organe unterversorgt sind.
DER FOTOBEWEIS: Die Spritzen, die da als "Impfungen"
bezeichnet werden, sind absolut giftig, und der
Beweis ist nun erbracht!
PHOTOGRAPHIC PROOF! The shots being referred to as
'vaccines' are absolutely poisonous, and the proof
is now here!
With healthy blood (left) the blood cells are like
billard balls and there is full 100% oxygen
transport, so the person is sportive and fit. The
blood cells of GENE vaccinated are crumpled, they
stick together forming clots and thromboses. AND:
oxygen transport is hardly possibble, eternal
tiredness comes up because all organs suffer lack of
oxygen.
www.StewPeters.tv | www.DrJaneRuby.com
Quelle / Source: Video auf Rumble:
https://rumble.com/vjw5kq-breaking-discovery-what-covid-injections-do-to-your-blood-doctor-releases-h.html
 Video mit dem
Blutbildvergleich: Blut von Gesunden und von
GENgeimpften, 15.7.2021 [19]
Video mit dem
Blutbildvergleich: Blut von Gesunden und von
GENgeimpften, 15.7.2021 [19]
========
GENimpfschaden
Schweiz 16.7.2021: Das Blut wird anders
Mara, [16.07.21 19:01]
BREAKING DISCOVERY! What COVID Injections Do To Your
BLOOD! Doctor Releases Horrific Findings!
MIRROR SOURCE:
https://www.bitchute.com/video/TxNfoBsMPrFK/?fbclid=IwAR17JSkjSnYd0DXX692UbsvBomkEoND9__mBIFyhOip9WPj-zafrFqGxXoI
========
Medizinisches: Blut
nach GENimpfung 20.7.2021: Das Blut nach
GENimpfung Corona hat Blutzellen
zerknittert+verklumpt - Arzt Philippe van
Welbergen in GB:
Arzt teilt schreckliche Bilder: So verändert der
Covid-Impfstoff das Blut
https://uncutnews.ch/arzt-teilt-schreckliche-bilder-so-veraendert-der-covid-impfstoff-das-blut/
Mara, [20.07.21
14:44]
[Weitergeleitet aus greedo_unzensiert]

GESUNDE Blutzellen - und GENgeimpfte Blutzellen:
Letztere sind verknittert und teilweise schon
verklumpt, Thrombosen kündigen sich an
Video-Link:
https://brandnewtube.com/watch/discovery-what-covid-injections-do-to-your-blood-dr-releases-horrific-findings_m1kR5B4RfZwfKCA.html
========
GENimpfschaden Schweiz
26.7.2021: Mann 2fach GENgeimpft hat Zecken, die
tot sind - da muss Nervengift im Blut von den
GENimpfungen sein!
Mara, [26.07.21 13:13]
https://t.me/Impfschaden_Corona_Schweiz/15675
Eine neue Meldung:
Liebe Mara
Ich habe auch etwas Bemerkenswertes zu berichten.
Vielen Dank für euren Einsatz!Bitte anonym posten:
Meine Mutter (ungeimpft) hat meinem (leider zweifach
geimpften) Vater neulich drei Zecken entfernen
müssen. Normalerweise sind die recht schwer zu
entfernen und leben noch, wenn man sie rausgezogen
hat. Diese drei allerdings waren alle schon
tot! Das erinnert mich an die gängigen
Mittel für Haustiere, welche man ihnen auf die Haut
aufträgt. Beisst sich dann eine Zecke fest, stirbt
sie sofort an diesem Nervengift. Fragt sich, was da
im Blut meines Vaters so toxisch gewirkt hat, dass
die Zecken daran zu Grunde gingen… Das ist
echt gruselig.
Ich hoffe so sehr, dass die Aufstände gegen all
diese freiheitsraubenden Massnahmen sich in aller
Welt mehren und dass wir alle gemeinsam gegen die
Treiber dieses Wahnsinns ankommen, sodass das so
bald wie möglich gestoppt werden kann! Es ist zum
Verzweifeln! Bleibt standhaft und haltet alle
zusammen, nur so haben wir eine Chance! Das Gute
muss und wird siegen ♥️
========
GENimpfschaden Genf SRK 27.7.2021:
Rotes Kreuz kontrolliert das Blut NICHT, ob es
von GENgeimpften stammt - Blutbanken werden
NICHT GETRENNT - KEINE Analyse wegen D-Dimeren
- Rotes Kreuz handelt FAHRLÄSSIG
Mara, [27.07.21 20:12]
https://t.me/Impfschaden_Corona_Schweiz/15785
Eine neue Meldung:
Liebe Mara, habe mal das Rote Kreuz in Bern
angeschrieben und ein paar Fragen gestellt. Nun
habe ich Antwort erhalten. Kurz gesagt, die
vertrauen auf das was ihnen unterbreitet wird.
Zudem sind keine Massnahmen hinsichtlich
Kontrolle des Blutes von Geimpften vorgesehen.
Auch werden die Blutbanken nicht getrennt in
Blut von Geimpften und Ungeimpften aufbewahrt.
Und dies obwohl es schon so viele Todesfälle und
Impfschäden bei den Geimpften gegeben hat.
Damals bei HIV, also bei Aids, hat das Rote
Kreuz wirklich noch Massnahmen ergriffen. Dies
scheint nun als unnötig angesehen zu werden.
Also ich möchte kein Blut eines Geimpften
erhalten wenn ich ein Operation machen muss.
Auch wird das Blut bezüglich den D-Dimeren nicht
analysiert. Wenn man die Ergebnisse von Sucharit
Bhakdi bezüglich dem Anwerfen der Blutgerinnung
kennt, scheint mir dies schon echt fahrlässig zu
sein.
========
GENimpfschaden Schweiz 28.7.2021: Blut von
Familienangehörigen für OP der Mutter
Mara, [28.07.21 08:47]
https://t.me/Impfschaden_Corona_Schweiz/15802
Eine neue Meldung:
Sali Mara
Habe die Nachricht von jemanden gelesen wegen der
Operation und Blut von geimpften. Meine Mutter muss
auch nächstens operiert werdern. Mache mir darüber
auch sorgen und frage mich, ob es als Angehörige geht
für sie vorzeitig Blut zu spenden. Weiss da jemand
mehr?
========
GENimpfschaden im Blut Schweiz 28.7.2021:
Familienangehörige können Blut spenden
Mara, [28.07.21 10:14]
https://t.me/Impfschaden_Corona_Schweiz/15806
[Antwort auf Mara]
Eine Meldung dazu aus der Gruppe:
Zum Thema Transfusionen bei einer OP noch ein Hinweis.
Zur Info für alle die eine Operation vor sich haben
und denen Fremdblut zu unsicher ist, ist eine
Eigenblutspende möglich. Die Erythrozytenkonzentrate
sind 5 Wochen haltbar, es können maximal 3 Spenden
gemacht werden, die letzte etwa 10 Tage vor dem
geplanten Eingriff und jeweils im Abstand von einer
Woche.
Allerdings darf der Hämoglobinwert nicht zu tief sein
und auch die Neubildung nicht gestört sein, der
Ferritinwert sollte sich im Normalbereich befinden
(Mit Ferrum phosporicum Schüssler Salze Nr.3 kann er
verbessert werden, allerdings ist eine längerfristige
Einnahme nötig).
Eine Eigenblutspende war bis vor 15 Jahren noch
gelegentlich üblich bei einer Knie- oder Hüft-OP, aus
meiner Erfahrung wird bei diesen Operationen nur noch
in Ausnahmefällen Spenderblut benötigt, weil die
Operationen minimalinvasiv geworden sind.
Der grösste Blutbedarf ist nicht planbar, im
Regionalspital wo ich arbeite, brauchen Unfälle und
Geburten selten Konserven, der Hauptanteil sind
onkologische Erkrankungen und in letzter Zeit mit
leicht steigender Tendenz GI-Blutungen (Magen-Darm)
und akute Abdomen.
Weitere Infos zur Eigenblutspende geben die
Blutspendezentren.
========
29.7.2021: Das Blut von GENgeimpften ist
eigentlich KEIN Blut mehr:
Doktor: Bedenkliches Ergebnisse
https://uncutnews.ch/bedenkliches-ergebniss-doktor/
<Ja, es ist an der Zeit, Ihr eigener „medizinischer
Ermittler“ zu werden, denn diese Impfstoffhersteller und
Zulassungsbehörden handeln nicht unser bestes Interess.
Möchten Sie genau wissen, was die mRNA-Impfstoffe mit
Ihrem Blut anstellen, das viel gefährlicher ist als das
Covid-19-Virus oder eine seiner Varianten?
Sie müssen kein Mechaniker sein, um zu lernen und zu
verstehen, wie schmutziges Öl einen Motor ruinieren
kann, und Sie müssen kein Arzt oder Wissenschaftler
sein, um zu verstehen, wie mRNA-Covid-Impfstoffe die
roten Blutkörperchen so verändern, dass sie
zusammenkleben. Das erklärt die
Blutgerinnsel-Phänomene, die auf der ganzen Welt nach
einer Covid-Impfung auftreten. Dies erklärt die
Epidemie von entzündeten Herzen, die nach der
Covid-Impfung rund um den Globus passiert. Dies
erklärt die Explosion der Fälle von neuromuskulären
degenerativen Erkrankungen.
Warum klagen
Abertausende von Covid-geimpften Menschen über
unerbittliche Lethargie, Schwindel und getrübtes
Denken?
Myokarditis ist der Zustand eines entzündeten
Herzens, das aus verschiedenen Gründen überlastet ist.
Ein Hauptgrund für Myokarditis, Schlaganfälle und
Herzinfarkte sind verstopfte Blutgefäße,
einschließlich Arterien, Venen und Kapillaren, von
denen jede eine spezifische Rolle im Prozess der
Zirkulation von Sauerstoff und Nährstoffen spielt.
Sogar einige der gesündesten Menschen auf dem Planeten
Erde, unsere Militärangehörigen, erleiden nach einer
Covid-Impfung eine Myokarditis, und das ist
wissenschaftlich in klinischen Studien belegt.
Unter einem normalen Mikroskop zeigt die Untersuchung
von Blutproben (Blutausstrich) von Patienten eines
Arztes, die die Moderna Covid-Impfung(en) erhalten
haben, Blutzellen, die zerstört sind,
mutiert-röhrenförmig aussehen und zusammenklumpen
(aggregiert). Diese Patienten und ihr Arzt wollen
genau wissen, was in ihren Blutkreislauf geschoben
wird und was nun in ihrem Körper zirkuliert?
Die Fehlinformationen kommen von Pfizer und Moderna
über mRNA und ihre wahre Funktion. Von dort stammen
alle Fehlinformationen nicht die alternativen
Nachrichten, wie MSM alle glauben machen möchte.
Diese Bilder von Blutausstrichen von Covid-geimpften
Patienten scheinen, als ob der Patient an
Guillain-Barre-Syndrom oder MS litt, aber das war
nicht der Fall. Wie verursachen die Impfstoffe diesen
Effekt? Der Moderna-mRNA-Covid-Impfstoff verändert die
Form und Klebrigkeit der roten Blutkörperchen, wodurch
sie gerinnt. Das erste Diagramm unten zeigt gesunde
Blutkörperchen und nach der Covid-Impfung haben Sie
mutierte, deformierte rote Blutkörperchen,
aufgestockte Proteine und den Klebrigkeitsfaktor, der
tödliche Blockaden verursacht. Es ist wie eine
Anhäufung von Hunderten von Wracks auf den Autobahnen
und Straßen, auf denen Ihr Blut fließt, 24/7/365.
Schau mal:
Eine schwere
Myokarditis, die durch die Covid-Impfstoffe
verursacht wird, schwächt Ihr Herz und verhindert
gleichzeitig, dass der Rest Ihres Körpers genügend
Blut bekommt
Die Covid-Impfstoffe sind überhaupt keine Impfstoffe.
Sie sind genmanipulierende, toxische Injektionen, die
das menschliche Blut verstopfen. Zufälligerweise ist
eine virale Infektion die häufigste Ursache für eine
Herzmuskelentzündung, so dass Covid die perfekte
Tarnung für Impfstoffe ist, die entzündete Herzen und
Blutgerinnsel verursachen. Während einer viralen
Infektion produziert Ihr Körper Zellen, um das Virus
zu bekämpfen, aber nach einem mRNA-Impfstoff
produzieren Ihre Zellen klebrige Proteine und Prionen,
die „Straßensperren“ in Ihren Blutgefäßen verursachen,
und Ihr Blut verstopft noch mehr um diese Hindernisse
herum. Das Problem wird verschlimmert und wird schnell
tödlich.
Einige Opfer der Covid-Impfung leiden an einer
Hirnvenenthrombose oder einer tiefen Venenthrombose.
Dies sind tödliche Blutgerinnsel im oder in der Nähe
des Gehirns. Andere Impfopfer leiden an Lungenembolien
direkt nach der Covid-Impfung. Diese entstehen durch
eine abnorme Gerinnung, bei der das gesamte
Blutgerinnungssystem gekapert wurde und dank der
mRNA-„Technologie“ außer Kontrolle gerät. Auch die
inneren Organe nehmen durch die Impfstoffe Schaden.
Wenn sich diese durch den Impfstoff verursachten
Gerinnsel von ihrem Entstehungsort lösen, können sie
zu einem Organ oder einer Arterie wandern, die dafür
zu eng ist, den Blutfluss blockieren und zu einer
Lungenembolie führen, wie es bei diesen Impfopfern in
der Lunge, im Magen und im Gehirn geschieht
(ischämische Schlaganfälle).
Die Forschung zeigt, dass Covid-19-Patienten auch
signifikant erhöhte Werte von Blutgerinnungsmolekülen
haben, die ebenfalls Gefäßerkrankungen begünstigen, so
dass sich das Problem für Leute, die Covid bekommen
haben und zusätzlich den Impfstoff bekommen, noch
verschlimmert, aber die CDC kümmert sich nicht darum.
Niemand wird auf irgendetwas überprüft, bevor er
Covid-Impfungen in verlassenen Einkaufszentren,
Sportveranstaltungen und Nachtclubs bekommt. Es ist
ein freies Spiel, weil die mRNA-Impfungen schmutzig,
schmutzig, schmutzig sind.
========
GENimpfschäden Schweiz 9.8.2021: Das Blut
ist kaputt: Blutkörperchen sind "angegriffen"
Impfschäden Schweiz Coronaimpfung, [09.08.21 13:57]
https://t.me/Impfschaden_Corona_Schweiz/16556
Eine neue Meldung:
heute beim hausarzt gewesen. er hatte gratuliert, dass
ich keine impfung mache. im gespräch mit ihm hat er
erklärt, was bei der impfung so passiert danach.
grundsätzlich werden durch die impfungen die
blutkörper "angegriffen" und das löst entsprechende
probleme wie nebenwirkungen aus. ihn wundert es
überhaupt nicht, dass jetzt so viele patienten seine
praxis nach der impfung aufsuchen. so ein gespräch mit
einem hausarzt, bestätigt einmal mehr, dass die
impfungen entsprechende probleme auslösen können.
hoffe das begreiffen nun auch alle die sich impfen
lassen hatten, oder es noch vor sich hätten.
========
Fascho-4R+Fascho-Frankreich
20.8.2021: Blut von GENgeimpften hat Klumpen drin:
DAS BLUT VON VIELEN GEIMPFTEN PATIENTEN WURDE
UNTERSUCHT UND SOWOHL IN FRANKREICH ALS AUCH IN
DEUTSCHLAND WURDE FESTGESTELLT, DASS DAS BLUT EINE
ROULEAUX-BILDUNG AUFWEIST.
https://t.me/oliverjanich/70135
Medizinisches im 4R am 20.8.2021:
GENimpfblut ist eine Katastrophe - Ärztin Gitala:
Gruppe von Ärzten aus Deutschland hat geimpften
Menschen Blut abgenommen, und die Ergebnisse sind
alarmierend
https://uncutnews.ch/gruppe-von-aerzten-aus-deutschland-hat-geimpften-menschen-blut-abgenommen-und-die-ergebnisse-sind-alarmierend/
Code zum Einbetten:
<div align="center"><iframe scrolling="no"
style="border: none;" src="https://www.bitchute.com/embed/nIhql9PJLL9K/" width="640" frameborder="0"
height="360"></iframe></div>
========
GENimpfschaden
Schweiz 25.8.2021: Blutgruppe bei GENgeimpften nicht
mehr bestimmbar?
Impfschäden Schweiz Coronaimpfung, [25.08.21 17:33]
https://t.me/Impfschaden_Corona_Schweiz/18109
[ Audiodatei : audio_2021-08-25_17-26-21.ogg ]
Eine neue Meldung:
Geimpfte leiden scheinbar unter Blutarmut und ihre
Blutgruppe lässt sich nicht mehr bestimmen
Kann das ein Arzt bestätigen?
========
Blutspenden Kanton Bern
26.8.2021: GENgeimpfte spenden Blut - ist hochgefährlich
- wenn möglich Eigenblut anlegen
Impfschäden Schweiz Coronaimpfung, [26.08.21 09:25]
https://t.me/Impfschaden_Corona_Schweiz/18184
Eine neue Meldung:
Zum Gruss an Alle, Mann ca. 65j. frisch von Blutspende
heute im Kt. Bern. Ja, über seine erfolgte Impfung (mehr
weiss ich nicht) wurde gesprochen. Aber nichts
aufgeschrieben. Bin nicht vom med. Fach. Aber wenn nötig
sich um Eigenblut kümmern.
========
Widerstand
27.8.2021: Wo ist die Organisation von UNgeimpften
Blutkonserven?
Impfschäden Schweiz Coronaimpfung, [27.08.21 16:29]
https://t.me/Impfschaden_Corona_Schweiz/18417
Eine neue Meldung:
weiss jemand, ob es in der Schweiz bereits eine Liste
für Ungeimpfte bzgl. allenfalls nötiger Blutspende
gibt? Ich möchte keinenfalls Blut von Geimpften - muss
man wohl auch in der Patientenverfügung festhalten!
Wäre froh um allfällige Infos.
Denn:
Oltener Zeitung
27.8.2021: Ab 7 Tagen nach der GENimpfung kann
man wieder Blut spenden - pervers!
Impfschäden Schweiz Coronaimpfung, [27.08.21
15:24]
https://t.me/Impfschaden_Corona_Schweiz/18412
[ Bild ]
Eine neue Meldung:
Liebe Mara, da können wir ungeimpften nur beten,
dass wir NIE eine Blutspende benötigen 😳 In der
Neue Oltener Zeitung vom 25.8 21 gelesen.
========
Video über Blut von GENgeimpften 29.8.2021:
Video zum Blut von GENgeimpften: Verschrumpelte
Blutkörperchen verklumpen - die Pharma muss das gewusst
haben - Anwalt und Prozess!
Impfschäden Schweiz
Coronaimpfung, [28.08.21 11:15]
https://t.me/Impfschaden_Corona_Schweiz/18515
Eine neue Meldung:
Hallo Mara.
Ich übertrage dir ein Video, das die ganze Grausamkeiten
und Hinterhältigkeiten dieser Impfung darlegt und wie
sie langsam das Blut der geimpften zerstört.
Etwas was im Video NOCH nicht behandelt wird ist:
Die roten Blutkörperchen sind verformbar. So, dass sie
auch duch die kleinen Kapillar Gefäße hindurchgehen.
Auch sind sie 'negativ' geladen. So stossen sie sich
gegenseitig ab, damit die GANZE Oberfläche für den
Sauerstoff Transport frei bleibt! Duch die Impfung
'verklumpen' sie sich und bilden so auch so 'kleine'
Trombosen' die zunächst unbemerkt bleiben! Mir soll
keiner sagen dass diejenigen, die das zusammen
'geschustert' haben nicht Bescheid wussten. Wir sollten
uns mit Anwälten zusammen tun, auch mit dem Corona
Ausschuss Kontakt aufnehmen um eine Klage zu starten,
die alle Gesetzes Artikel, wie Nötigung, das Volk in
Angst und Schrecken versetzen, sowie das Eindringen der
Arbeitgeber in die Med. Privatsphäre der Arbeitnehmer
zur Klage zu bringen. Ich übertrage dir nun das
Blutgerinnung
und Wundheilung 28.8.2021: GENgeimpfte brauchen 20 bis
40% länger für die Wundheilung
Impfschäden Schweiz Coronaimpfung, [28.08.21 11:14]
https://t.me/Impfschaden_Corona_Schweiz/18514
Eine neue Meldung eines Arztes:
Zu dem Beitrag über die Chirurgen muss ich sagen, 3
Wochen reichen nicht. Ich hatte Anfang Juni zwei
Geimpfte mit im OP. Die eine im März zweimal geumpft,
die zweite im Mai, also 3 Wocven vor der OP fertig.
Normalerweise ist die Wundheilung bei der OP nach 6
Wochen abgeschlossen. Die im März Geimpfte hat 8 Wochen
gebraucht, die 3 Wochen vorher Geimpfte 10 Wochen.
========
4R (es war einmal
ein Deutschland) 29.8.2021: Blutspende geht nur
mit UNgeimpften
https://t.me/Impfschaden_Corona_Schweiz/18501
(Fortsetzung)
Blutspende von Ungeimpften wäre wichtig! In
Deutschland dürfen nur Ungeimpfte spenden! Aber wenn
man doch durchimpfen muss? : …es wird Blut in den
Blutbanken fehlen und Menschen werden sterben.
========
GENimpfschaden Schweiz 29.8.2021: Frau (in
Menopause) hat nach GENimpfung wieder starke Mens - Mann
(60) GENgeimpft schlechte Wundheilung - Mann (30) nach
GENimpfung: Koma - Frau (60) nach GENimpfung: Blutbild=Chaos
- Frau (50) GENgeimpft: Gelenkschmerzen - Frau (65)
GENgeimpft: Morbus Bechterew - oft Fanatismus und
Kommunikationsunfähigkeit - graue Gesichter,
speckig-fettig, verschwitzt, aggressiv
Impfschäden Schweiz Coronaimpfung, [29.08.21 11:06]
https://t.me/Impfschaden_Corona_Schweiz/18635
Fortsetzung:
nun habe ich noch ein paar impfwirkungen zu melden
Frau knapp 50 (menopause) : hat ihre blutung wieder sehr
stark
mann 60: OP: wunde verheilit nicht gut
Mann 30 nach impfung: im koma
frau 60 : blutbild total durcheinander. verdacht:
krebszellen wieder ausgebrochen : fehlalarm
frau 50: schmerzen in gelenken wie aus dem nichts
frau 65: morbus bechterew plötzlich
und was mir noch aufgefallen ist. viele haben eine extrem
starren blick und können nicht mehr auf andere eingehen
und sind so fanatisch von dem ganzen überzeugt!
ich umgebe mich nicht mehr gerne mit geimpften! sie habe
eine ganz komische ausstrahlung, grau-kartonfarbige
gesichtsfarbe, Speckig-fettige haut, verschwitzes gesicht!
und sind teils fast aggressiv im verhalten in gesprächen.
========
Blutbild Schweiz 30.8.2021: Blutbild von
GENgeimpfte ist verändert, aber noch bestimmbar
Impfschäden Schweiz Coronaimpfung, [30.08.21 13:42]
https://t.me/Impfschaden_Corona_Schweiz/18796
[Antwort auf Impfschäden Schweiz Coronaimpfung]
Eine Meldung eines Arztes:
Man zeigen tatsächlich Veränderungen im Blutbild, v.a.
Bezüglich der weissen Blutkörperchen. Die
Blutgruppenbestimmung ist trotzdem möglich.
========
GENimpfwahn mit Graphen
im Blut 30.8.2021
Impfschäden Schweiz Coronaimpfung, [30.08.21 16:31]
https://t.me/Impfschaden_Corona_Schweiz/18835
[Weitergeleitet aus Dr Jane Ruby (Dr Jane Ruby)]
How about a little misty graphene bomb and look at
how your red blood cells react! They start sticking
together and forming in stacks… No wonder people are
exhausted, tired, weak no oxygen!!
 GENimpfwahn mit Graphen im Blut
30.8.2021 [20]
GENimpfwahn mit Graphen im Blut
30.8.2021 [20]
========
2.9.2021: Blut von GENgeimpften ohne
Antikörper - oder mit Antikörper und gestorben
Impfschäden Schweiz Coronaimpfung, [02.09.21 13:59]
https://t.me/Impfschaden_Corona_Schweiz/19264
[ Audiodatei : labor (online-audio-converter.com).mp3 ]
Hier ein Bericht von jemand welcher eine Laborantin kennt
welche das Blut von Geimpften untersuchen und eine Studie
machen. Fazit - die meisten Geimpften entwickeln keine
Antikörper, können also weiterhin angesteckt werden bzw. das
Virus weiter geben und die welche Antikörper entwickelt
haben sind gestorben. Wann steht das medizinische Personal
einmal auf und wehrt sich gegen diese Menschenversuche und
die Impfkampagne ?
========
GENimpfschaden Schweiz 3.9.2021: Blut bei
GENgeimpften ist kaputt - Video - der Blind-Blick nennt
das Fake-News
https://www.blick.ch/schweiz/zuerich/zahl-der-geimpften-auf-intensivstationen-wird-angeblich-verheimlicht-ostschweizerin-entlarvt-skeptiker-video-als-fake-news-id16800440.html
Impfschäden Schweiz Coronaimpfung, [03.09.21 10:33]
[Weitergeleitet aus Freies Forum Schweiz (Hanspeter)]
Zum Blick Artikel von heute - das Video von dem sie reden
wurde vorgestern Abend veröffentlicht und ist total viral
gegangen. Inzwischen wurde es von YouTube genommen kursiert
aber weiterhin auf anderen Plattformen. Das Blick hier
reagiert, zeigt, dass man es als Bedrohung ansieht und die
Info's welche in dem Video zu hören waren, sind natürlich
explosiv. Man hört aber sehr ähnliche Meldungen aus anderen
Ländern, anderen Spitälern und aus anonymen Chats von
Pflegekräften. Das Problem in dem Video war, dass ein Name
zu hören war und das darf dann eben nicht sein, weil dann
wird es konkret. Freies Forum Schweiz ist über die
Hintergründe dieses Video informiert und wir denken dass die
Information korrekt waren. Es gab auf Grund der ersten
Sprachnachricht, welche an andere Leute privat
weitergeleitet wurden, mehrere andere Nachrichten von
Menschen, welche ähnliches aus ihrem Umfeld berichtet haben.
In einem Fall hat sich jemand gemeldet, welcher meldete dass
in Laboren, wo das Blut von Geimpften untersucht wurde sehr
bedenkliche Resultate festgestellt wurden. Es gibt viele
solche Meldungen. Das Problem ist, alle reden nur anonym,
weil sie berechtigte Angst haben ihren Job zu verlieren. Der
Aufruf geht aber an alle Pflegekräfte. Ihr müsst
zusammenstehen und öffentlich zur Wahrheit stehen. Wenn sich
nur eine Person meldet, dann ist klar wird man sofort
diffamiert und entlassen. Dass die in der Sprachnachricht
genannte Frau sofort dementiert hat ist ja klar. Sie musste
ihre Tochter schützen. Die Sprachnachricht war auch nicht
für die Öffentlichkeit gedacht und ist wegen eines "
unglücklichen " Zufalls halt nun in die breite
Öffentlichkeit gelangt. Vielleicht musste es ja so sein,
aber der Punkt ist. Die Leute welche in der Pflege arbeiten
müssen zusammen aufstehen und die Wahrheit berichten.
========
GENimpfschaden Blutbild Schweiz 4.9.2021:
Verklumpung der roten Blutkörperchen: Kaum noch
Sauerstofftransport und Thrombosen
Impfschäden Schweiz Coronaimpfung, [04.09.21 13:48]
https://t.me/Impfschaden_Corona_Schweiz/19553
Eine neue Meldung:
Also ich kann dazu noch folgendes sagen: Das Blutbild
praktisch aller Geimpften weist ein Verklumpen der roten
Blutkörperchen aus. Damit sinkt die Oberfläche dieser! Die
Folge ist nur logisch = verminderte Sauerstoff Versorgung
und Trombosen.
Und noch eine Frage an Frau Rickli: "Liebe Frau Rickli.
Gehen sie sich doch AUCH aber bitte mit einem ECHTEN (nicht
Kochsalz Lösung), Impfstoff impfen. Und das öffentlich! Sie
lieben ja die Aufmersamkeit, koste es was es wolle!"
========
GENimpfschaden Schweiz 5.9.2021: GENgeimpfte
werden zum Blutspenden abgelehnt
https://t.me/Impfschaden_Corona_Schweiz/19646 (Fortsetzung)
Und in den vergangenen Tagen einfach zu viele Fälle von
Impf“neben“wirkungen gehört .. von Veränderung des
Thrombozyten-Blutbild und aufgrund dessen Ablehnung beim
Blutspenden -
========
GENimpfschaden Blut von GENgeimpften Schweiz
9.9.2021: Blutspenden findet weiter OHNE Kontrolle statt
Impfschäden Schweiz Coronaimpfung, [09.09.21 16:27]
https://t.me/Impfschaden_Corona_Schweiz/20399
[Antwort auf Impfschäden Schweiz Coronaimpfung]
![GENimpfschaden Blut von GENgeimpften Schweiz
9.9.2021: Blutspenden findet weiter OHNE Kontrolle
statt [20] GENimpfschaden Blut von GENgeimpften
Schweiz 9.9.2021: Blutspenden findet weiter OHNE
Kontrolle statt [20]](../../coronavirus/d/me119-ab-7sep2021-d/020-CH-blutspenden-ist-weiterhin-ohne-3G-zertifikat-9sep2021.jpg)
GENimpfschaden Blut von GENgeimpften Schweiz 9.9.2021:
Blutspenden findet weiter OHNE Kontrolle statt [20]
"Vielen Dank für Ihre Anfrage. Das Blutspenden findet nach
wie vor unter den gültigen Schutzkonzepten ohne
Zertifikatspflicht statt. Freundliche Grüsse, Doris
Epprrecht, Spenderbüro"
========
GENimpfschaden Schweiz 11.9.2021: Bub
GENgeimpft hat katastrophale Blutwerte
Impfschäden Schweiz Coronaimpfung, [11.09.21 11:29]
https://t.me/Impfschaden_Corona_Schweiz/20734
Eine neue Meldung:
Polyneuropathie have ich seit 13 Jahren bin jetzt in
Behandlung bei einer heilpraktikerin sie ist Ärztin und
arbeitet alternativ am Donnerstag war ich das erste mal bei
ihr, ihr Sohn hat sich impfen lassen jetzt versucht sie es
ihm auszuleihen sie hat ihrem Sohn Blut abgenommen und seine
Werte sind katastrofal
========
GENimpfschaden
Blutschäden nach GENimpfung 14.9.2021: Beispiel
Blutbilder nach 2. tödlicher GENimpfung
Impfschäden Schweiz Coronaimpfung, [14.09.21 14:29]
https://t.me/Impfschaden_Corona_Schweiz/21273
Ein neuer Leak aus meinem Netzwerk! Die Tochter einer
befreundeten Psychologin hat ihren zweiten Schuss bekommen
und das Blut untersuchen lassen. Seht selbst!
Weitere Leaks und Skandale wurden bereits veröffentlicht
und weitere sind in Arbeit! Geht hierzu in die Achtung
Achtung Gruppe oder meinen Telegram Kanal.
Da uns Gott nur hilft, wenn wir uns selbst helfen, bitte
ich jeden selber aktiv zu werden.🇨🇭❤️🥋🇨🇭 Werdet
selbst zu Investigativ- Journalisten und zu einer Art
Volks Kripo, wenn international orchestriert Polizei und
Staatsanwaltschaften solchen Verbrechen gegen die
Menschlichkeit, Volk und Verfassung tatenlos zuschauen und
Politik, Medien, Behörden und gekaufte Wissenschaft und
Prominenz diese schwersten Verbrechen voran- und
weitertreiben. Schickt es selbst raus in alle Welt oder
meldet euch anonym bei Menschen mit #Mut und Reichweite.
Die sog. Pandemie der sog. Ungeimpften und das wir
ungespritzen die ICUs belegen würden, ist eine weitere
Lüge in diesem riesigen Betrug!
=============
GENimpfschaden
im Blutbild einer GENgeimpften Person
15.9.2021: 9 Fotos
Impfschäden Schweiz
Coronaimpfung, [15.09.21 13:19]
https://t.me/Impfschaden_Corona_Schweiz/21521
[Weitergeleitet aus Holger Fischer
Rechtsanwalt (Maya Stella)]
Im folgenden wieder Blutbilder von Blut von
Geimpften, mit Verunreinigungen
(Dunkelfeldmikroskopie) |
GENimpfschaden
im Blutbild 15.9.2021: Foto 1
Impfschäden Schweiz Coronaimpfung, [15.09.21
13:19]
https://t.me/Impfschaden_Corona_Schweiz/21522
[Weitergeleitet aus Holger Fischer Rechtsanwalt
(Maya Stella)]
Scheibenartiges Gebilde mit leuchtenden Punkten

GENimpfschadne im Blutbild 15.9.2021: Foto 1
[37] |
GENimpfschaden
im Blutbild 15.9.2021: Foto 2
Impfschäden Schweiz Coronaimpfung, [15.09.21
13:19]
https://t.me/Impfschaden_Corona_Schweiz/21523
[Weitergeleitet aus Holger Fischer Rechtsanwalt
(Maya Stella)]
Scheibenartige Form mit Spike Proteinen (?)

GENimpfschaden im Blutbild 15.9.2021: Foto 2
[38]
|
GENimpfschaden
im Blutbild 15.9.2021: Foto 3
Impfschäden Schweiz Coronaimpfung, [15.09.21
13:19]
https://t.me/Impfschaden_Corona_Schweiz/21524
[Weitergeleitet aus Holger Fischer Rechtsanwalt
(Maya Stella)]
Seltsame Form über den Erys

GENimpfschaden im Blutbild 15.9.2021: Foto 3
[39] |
GENimpfschaden
im Blutbild 15.9.2021: Foto 4
Impfschäden Schweiz Coronaimpfung, [15.09.21
13:19]
https://t.me/Impfschaden_Corona_Schweiz/21525
[Weitergeleitet aus Holger Fischer Rechtsanwalt
(Maya Stella)]
Seltsame Form im Blut Erys wirken wie tot

GENimpfschaden im Blutbild 15.9.2021: Foto 4
[40] |
GENimpfschaden
im Blutbild 15.9.2021: Foto 5
Impfschäden Schweiz Coronaimpfung, [15.09.21
13:19]
https://t.me/Impfschaden_Corona_Schweiz/21526
[Weitergeleitet aus Holger Fischer Rechtsanwalt
(Maya Stella)]
Stechapfelformen

GENimpfschaden im Blutbild 15.9.2021: Foto 5
[41] |
GENimpfschaden
im Blutbild 15.9.2021: Foto 6
Impfschäden Schweiz Coronaimpfung, [15.09.21
13:19]
https://t.me/Impfschaden_Corona_Schweiz/21527
[Weitergeleitet aus Holger Fischer Rechtsanwalt
(Maya Stella)]
spitze Gebilde

GENimpfschaden im Blutbild 15.9.2021: Foto 6
[42]
|
GENimpfschaden
im Blutbild 15.9.2021: Foto 7
Impfschäden Schweiz Coronaimpfung, [15.09.21
13:19]
https://t.me/Impfschaden_Corona_Schweiz/21528
[Weitergeleitet aus Holger Fischer Rechtsanwalt
(Maya Stella)]
Unbekanntes Objekt im Blut

GENimpfschaden im Blutbild 15.9.2021: Foto 7
[43]
|
GENimpfschaden
im Blutbild 15.9.2021: Foto 8
Impfschäden Schweiz Coronaimpfung, [15.09.21
13:19]
https://t.me/Impfschaden_Corona_Schweiz/21529
[Weitergeleitet aus Holger Fischer Rechtsanwalt
(Maya Stella)]
unnatürliche Form

GENimpfschaden im Blutbild 15.9.2021: Foto 8
[44] |
GENimpfschaden
im Blutbild 15.9.2021: Foto 9
Impfschäden Schweiz Coronaimpfung, [15.09.21
13:19]
https://t.me/Impfschaden_Corona_Schweiz/21530
[Weitergeleitet aus Holger Fischer
Rechtsanwalt (Maya Stella)]
vermehrt hell leuchtende Gebilde

GENimpfschaden im Blutbild 15.9.2021: Foto 9
[45] |
|
=============
Blut verklumpt
transportiert keinen Sauerstoff mehr 20.9.2021
Impfschäden Schweiz Coronaimpfung, [20.09.21 08:47]
https://t.me/Impfschaden_Corona_Schweiz/22257
[Antwort auf Impfschäden Schweiz Coronaimpfung]
Eine Meldung dazu:
Ich kann es nur erneut wiederholen: Wie zu Teufel sollen
verklumpte rote Blutkörperchen, die wie eine Münzen Rolle
aussehen, für die Sauerstoff Versorgung noch Gewähr
übernehmen? Und dazu, da sie durch die Verklebung nicht
mehr verformbar sind durch die Kapillar Gefäße hindurch
kommen???
Die Symptome sind doch eindeutig. Keine Kondition
(Sauerstoff Mangel) und (Kopfschmerzen) kleine Infarkte im
Gewebe. Eine weiterer Folge von O Mangel im Gehirn =
Konzentrations Schwäche! Es gibt Möglichkeiten dagegen.
Blut von GENgeimpften bei der Dialyse
(4R) 20.9.2021: Blut gerinnt, Maschinen verklumpen, das
Blut wird schwarz und es muss Heparin eingesetzt werden
Impfschäden Schweiz Coronaimpfung, [20.09.21 11:24]
https://t.me/Impfschaden_Corona_Schweiz/22284
Zitat:
Ich bin selbst eine Dialyseschwester und
habe das selbst gesehen. Das Blut meiner letzten beiden
Patienten, bevor ich meinen Job verlor, begann zu
gerinnen, die Maschinen verklumpften [stockten] und es
[das Blut der GENgeimpften] wurde fast schwarz. ich musste
Heparin bei beiden verwanden, das musste ich noch nie. Und
die Maschinen verklumpten [stockten] immer noch...

Blut von GENgeimpften bei der Dialyse 20.9.2021: Blut
verklumpt und wird schwarz [39]
========
GENimpfschaden Blut in der Schweiz
20.9.2021: Bluttest vor und nach der GENimpfung - Blut ist
jetzt total verändert+miserabel
Impfschäden Schweiz Coronaimpfung, [20.09.21 11:56]
https://t.me/Impfschaden_Corona_Schweiz/22295
Eine neue Meldung:
Meine Freundin sagte mir: ihre Kundin hat einen Blut Test
gemacht bevor und nach 💉. Sie war selbst überrascht über
die Bilder und Veränderung in ihre Blut. Sie weißt es ist
💉schuld aber es ist zu spät.
========
GENimpfschaden Schweiz 22.9.2021:
GENgeimpfte Leute haben Gelenkschmerzen+plötzlich sind die
Blutwerte im Keller
Impfschäden Schweiz Coronaimpfung, [22.09.21 13:05]
https://t.me/Impfschaden_Corona_Schweiz/22641
Eine neue Meldung:
Hallo Mara, seit mein Partner sich impfen ließ, bekam ich
schlimme Hustenanfälle, flache Atmung & immer wieder
Gelenkschmerzen im Knie-, Daumenbereich. Ich habe mal von
dem Begriff Shedding gelesen. Seit einer Woche nehme ich
Präparate, die Sheddingsymptome bekämpfen sollen. Sie
scheinen mir zu helfen.
Ich finde es entsetzlich wie perfide +skrupellos diese
Mörderkabale + psychopathen gates, schwab, soros, rothschild
und co. in ihrer Entschlossenheit vorgehen die weltweite
Bevölkerung zu DEZIMIEREN ‼️‼️‼️
Er selber beklagt sich immer wieder über Gelenkschmerzen.
Genauso in diesem Moment bekomme ich mit, daß seine dumme,
naive, skrupellose schwester, die für chf39/Stunde, die
Gift💀⚰️spritze💉einjagt und somit als Mittäterin beim
GENOZID mitschuldig ist, plötzlich auch an Gelenkschmerzen
leidet und ihre Blutwerte sind plötzlich völlig im Keller.
Ein Monat davor war ihre Blutwerte noch vollkommen in
Ordnung. Die Ärztin ist völlig fassungslos und kann es nicht
erklären wie ihre Blutwerte plötzlich alles krankhaft
ausfallen.
Es tut mir leid, aber irgendwie freue ich mich dies zu
erfahren. Es gibt doch tatsächlich Karma und Karma schlägt
zurück. Früher oder später wird man zudem für seine
Arroganz, stolz auf die eigene Dummheit zu sein, kaltblütige
Skrupellosigkeit, Egoismus, Opportunismus Konsequenzen
spüren. Ich wurde nämlich von der ganzen Sippe als dumme,
ignorante Verschwörungstheoretikerin &
Stammtischrednerin difammiert, denunziert und etikettiert.
========
Medizinisches Blutbild
27.9.2021: Normales Blut ist rot - Blut von GENgeimpften
ist dunkelbraun
https://www.facebook.com/photo?fbid=218849706975498&set=a.123904226470047

Medizinisches Blutbild 27.9.2021: Normales Blut ist rot
- Blut von GENgeimpften ist dunkelbraun [13]
========
Blutspenden von GENgeimpften 29.9.2021: Kr.
Rotes Kreuz Aargau-Solothurn hat die FANTASIE, der
GENimpfstoff sei "abgebaut" und auch GENgeimpfte können
Blut spenden
Impfschäden Schweiz Coronaimpfung, [29.09.21 13:09]
https://t.me/Impfschaden_Corona_Schweiz/23340
Eine neue Meldung:
Habe mich mal bezüglich Blutspende schlau gemacht. Hier die
Antwort vom SRK AG-SO:
je nach Impfstoff ist eine Spende nach einer Wartefrist von
2 Tagen (Impfstoffe mit inaktivierten Viren, z.B.
mRNA-Impfstoff) oder 4 Wochen (Impfstoffe mit abgeschwächten
Viren) wieder möglich. Falls nach Verabreichung der Impfung
Symptome entwickelt werden, ist eine Blutspende erst 7 Tage
nach vollständigem Abklingen der Symptome wieder möglich.
Sollten man nicht wissen was für einen Impfstoff man
erhalten hat, darf man dies nachfragen am Ort wo man sich
geimpft hat, ansonsten ist die Rückweisungsfrist 4 Wochen.
Es kann davon ausgegangen werden, dass der entsprechende
Impfstoff gemäss oben genannten Karenzzeiten, nach Ablauf
ebendieser, zum Zeitpunkt der Blutspende im Blut des
Spenders abgebaut ist – insofern wird hier also, unter
Einhaltung des zuvor genannten Rahmens,
kein weiterer
Unterschied zwischen geimpften und ungeimpften
Blutspendern und ihren Blutspenden gemacht.
Liebe Grüsse vom Blutspendeteam
========
"USA" 5.10.2021: Blutuntersuchung von
GENgeimpften wie gehabt:
Never Before Seen: Blood Doctor Reveals HORRIFIC Findings
After Examining Vials
The Stew Peters Show
Link:
https://www.redvoicemedia.com/2021/10/never-before-seen-blood-doctor-reveals-horrific-findings-after-examining-vials/
========
GENgeimpfte Menschen mit schweren
Nebenwirkungen in Südafrika 6.10.2021: Gestapelte
Blutzellen und schwarze Strukturen im Blut - Ärztin Zandre
Botha:
Purer Horror: Arzt entdeckt mysteriöse „schwarze
Strukturen“ im Blut von geimpften Patienten
https://uncutnews.ch/purer-horror-arzt-entdeckt-mysterioese-schwarze-strukturen-im-blut-von-geimpften-patienten/

Video auf Rumble (4.Okt.2021): https://rumble.com/vnbgal-never-before-seen-blood-doctor-reveals-horrific-findings-after-examining-vi.html
Video auf Bitchute (6.Okt.2021): https://www.bitchute.com/video/Sffxfn2Q7RGA/
Video auf VK (7.Okt. 2021): https://vk.com/video472868156_456239639
Video auf GloriaTV (5.Okt.2021): https://gloria.tv/post/CYb3Qraejiiy2SRLNkusqEjaC
Immer mehr Patienten der südafrikanischen Ärztin Zandre
Botha leiden nach der Corona-Impfung unter
Nebenwirkungen. Dazu gehören Thrombosen, Embolien,
kognitive Probleme, Nervenschmerzen und Kurzatmigkeit.
Sie beschloss, das Blut ihrer Patienten unter dem
Mikroskop zu untersuchen und war schockiert.
Die roten Blutkörperchen der Geimpften seien bis zur
Unkenntlichkeit deformiert, sagte Dr. Botha in der Stew
Peters Show. „Das habe ich noch nie gesehen. Ich war
schockiert“, sagte die Ärztin, die seit 15 Jahren in
diesem Bereich tätig ist.
Schwarze Strukturen
Außerdem fand sie bei allen geimpften Patienten mit
Symptomen „schwarze Strukturen“ im Blut. „Ich war sehr
schockiert“, sagte sie.
Botha gelang es auch, einen Janssen-Impfstoff in die
Hände zu bekommen und dessen Inhalt unter dem Mikroskop zu
untersuchen. „Ich war sehr schockiert, denn was ich im
Blut meiner Patienten fand, war auch im Impfstoff
enthalten“, sagte sie. Sie bezog sich auf die schwarze
Substanz, die aus zahlreichen Scheiben mit Löchern
besteht.
Der Arzt entdeckte auch seltsame rechteckige Strukturen
in dem Impfstoff. „Ich weine, wenn ich solche Dinge sehe.
Ich weine, wenn diese Patienten reinkommen“. Sie sagte,
einer ihrer Patienten habe innerhalb von fünf Stunden nach
der Impfung acht Herzinfarkte erlitten und liege nun auf
der Intensivstation. „Ich hoffe, ich kann ihm helfen.“
Letzte Woche wurde der Beipackzettel für den Impfstoff
Corona von Janssen um den Hinweis auf eine venöse
Thrombose, ein Blutgerinnsel in einer Vene, ergänzt.

Dr. Zandre Botha in Südafrika entdeckt das zerstörte Blut
der GENgeimpften mit schweren Symptomen und schwarzen
Objekten drin [17]
The video: Südafrika 4 Okt.2021: Blutbild v
GENgeimpften m schweren Symptomen - blood vaxxed w heavy
symptoms (21'24'')
The video: Südafrika 4 Okt.2021: Blutbild v GENgeimpften
m schweren Symptomen - blood vaxxed w heavy symptoms
(21'24'')
https://www.bitchute.com/video/Sffxfn2Q7RGA/
- Bitchute-Kanal: NatMed-etc. - hochgeladen am 6.10.2021


Südafrika: Ärztin Zandre Botha: Hier sind intakte
Blutzellen wie Billardkugeln [13] - Südafrika: Ärztin
Zandre Botha: Blutzellen sind gestapelt und bilden
Thrombosen [14]


Südafrika: Ärztin Zandre Botha: Schwarzes Objekt wie eine
Schildkröte im Blut [15] - Südafrika: Ärztin Zandre Botha:
Schwarzes Objekt wie ein schwarzes Wildschwein im Blut
[16]
Medizinisches 8.10.2021: Blutvergleich
gesundes rotes Blut und GENgeimpftes schwarze Blut ohne
Hämoglobin
Impfschäden Schweiz Coronaimpfung, [08.10.21 10:15]
https://t.me/Impfschaden_Corona_Schweiz/24702

Medizinisches 8.10.2021: Blutvergleich gesundes rotes Blut
und GENgeimpftes schwarze Blut ohne Hämoglobin [29]
8.10.2021: Die Frage, ob Mücken
Spike-Proteine der GENgeimpften übertragen können: NEIN!
Impfschäden Schweiz Coronaimpfung, [18.10.21 16:52]
https://t.me/Impfschaden_Corona_Schweiz/25895
[Antwort auf Impfschäden Schweiz Coronaimpfung]
Eine Meldung dazu:
Darauf habe ich eine Antwort: Ich kenne einen Fall, wo ein
Sohn seinem gespritzten Vater 4 Zecken abgenommen hat,
nachdem dieser im Wald gearbeitet hat. Alle vier waren tot.
Normalerweise leben die noch. Auch einen Fall mit einer
Mücke kenne ich.
Mücke noch während des Stechens
gestorben. Somit rechne ich damit, dass diese
Tiere es nicht zu einem Ungespritzten schaffen, um diesem zu
schaden, weil sie vorher sterben. Ob das immer so ist oder
nur eine gewisse Zeit nach der Injektion, weiss ich auch
nicht. Was mir aber grosse Sorgen bereitet, ist die
Bluttransfusion, da das Blut der Gespritzten mit dem der
Ungespritzten vermischt wird, wie mir das Rote Kreuz Schweiz
und der Schweizerische Samariterbund auf Nachfrage
mitteilten.
GENimpfschaden Schweiz 27.10.2021: Frau (21)
GENgeimpft: Blutblasen an den Beinen, ev. Fussamputation
Impfschäden Schweiz Coronaimpfung, [27.10.21 09:08]
https://t.me/Impfschaden_Corona_Schweiz/27109
Eine neue Meldung:
Liebe Mara. Ich kämpfe. Will ich eigentlich nicht . Ich
kämpfe um die Menschen die ich über alles liebe . Mein Sohn
will sich jetzt testen lassen. Sein geimpfter Vater will mit
ihm Metzgete essen Restaurant und dann an den FCB
Match nächste Woche . Ich bin unendlich traurig darüber dass
man als vater nur an sein Vergnügen denkt und die Gesundheit
des Sohnes so ausser acht lässt . Dazu muss ich sagen dass
mein Sohn seit Geburt Stimmbandlähmung und Muskelschwäche
hat und mit drei Jahren fast an einer pneumokokken Impfung
gestorben ist nach einem tracheostoma. Heute merk man ihm
das kaum mehr an aber er hat seine Einschränkungen. Heute
sagte er zu mir er wäre am liebsten nicht mehr da bei der
ganzen scheisse . Wissen eigentlich alle impffanatiker und
Politiker was sie unserer Jungend antun ???? Ich könnte
schreien .
Die nichte einer Freundin sie ist 21 , liegt im Spital und
ihre Beine sind übersäht mit blutblasen nach der Impfung .
Vielleicht verliert sie ihren Fuss . Da Bild dazu erspar ich
euch .
Meine Mutter in Deutschland überlegt sich jetzt doch die
Impfung . Weil vielleicht 2 G kommt. Und sie nicht ins
Restaurant kann . Etc..
ich bin müde . Ich bin gesund und hab nix. Ich werde
ausgeschlossen wie so viele . Ich hab während lockdown 150 %
gearbeitet . Da hat man uns noch beklatscht . Scheiss drauf
. Jetzt hoff ich dass wir genug sind die den Kopf aufmachen
und am 28.11. ein klatschendes nein stimmen . Wenn nicht
musss ich mir überlegen wohin ich auswandern kann. Ich hab
keinen Bock mich der Willkür bis 2031 von
grössenwahnsinnigen Psychopathen auszusetzen . Und bei der
nächsten Demo bin ich dabei. Mein Sohn sagte Mam warum ? Ich
hab gesagt für unsere Freiheit mein Sohn . Ich bewundere
alle die bisher demonstriert haben . Raus aus der
Kompfortzone. Fertig lustig 🙏
GENimpfschaden 4R
28.10.2021: Neue Blutkrankheit:
Warnung aus Westdeutschem Tumorzentrum: Seit Impfbeginn
vermehrt seltene Blutkrankheit
https://report24.news/warnung-aus-westdeutschem-tumorzentrum-seit-impfbeginn-vermehrt-seltene-blutkrankheit/?feed_id=6813
Video von Dr. Richard Fleming (englisch)
28.10.2021: Blutuntersuchung rote Blutzellen (gesund) und
weisse (tot) - UND 2. Teil des Videos: Untersuchung der
Pfizer-Impfung mit Fremdkörpern
https://www.bitchute.com/video/QlUJx1xxPKWW/
https://t.me/Impfschaden_Corona_Schweiz/27263
Impfschäden Schweiz Coronaimpfung, [28.10.21 08:42]
Guten Morgen
Was in den Impfstoffen genau enthalten ist, ist umstritten.
Dr. Richard Fleming hat den Pfizer-Impfstoff mikroskopisch
untersucht. Er sagt, es seien KEINE Microchips, Parasiten
oder Graphine enthalten. ABER die Impfstoffe seien stark
verunreinigt und verursachen Blutgerinnsel. Sie hätten
definitiv aus Qualitätsgründen nicht zugelassen werden
dürfen - auch nicht mit Notfallzulassung.
Video: Blood Tests Reveal And
Confirm Covid Vaccines Unsafe For Humans (30'36'')
Video: Blood Tests Reveal And Confirm
Covid Vaccines Unsafe For Humans (30'36'')
https://www.bitchute.com/video/QlUJx1xxPKWW/ -
Bitchute-Kanal: AngelusCaelis - hochgeladen am
27.10.2021
1G-Fascho-Australien 29.10.2021: Interview
mit Dr. Peggy - Pathologin mit komischem Blut von
GENgeimpften Personen unter dem Mikroskop:
AUSTRALIAN 'SPIRO INTERVIEWS DR PEGGY A PATHOLOGIST ABOUT
THE BIZARRE BLOOD OF VACCINATED PATIENTS
Video-Link:
https://www.bitchute.com/video/PrIrQ99EN2Po/
https://t.me/Impfschaden_Corona_Schweiz/27405
Australian 'Spirointerviews Dr Peggy a pathologist about the
bizarre blood of vaccinated patients
Video: AUSTRALIAN 'SPIRO INTERVIEWS
DR PEGGY A PATHOLOGIST ABOUT THE BIZARRE BLOOD OF
VACCINATED PATIENTS (25'2'')
Video: AUSTRALIAN 'SPIRO INTERVIEWS DR PEGGY A PATHOLOGIST
ABOUT THE BIZARRE BLOOD OF VACCINATED PATIENTS (25'2'')
https://www.bitchute.com/video/PrIrQ99EN2Po/ -
Bitchute-Kanal: PCS - hochgeladen am 16.9.2021
GENimpfschaden Schweiz
5.11.2021: Frau 4fach GENgeimpft hat wieder Corona -
Mann 2fach GENgeimpft mit OP, Wundstillung kaum möglich
Impfschäden Schweiz Coronaimpfung, [05/11/2021 01:50 P.M.]
https://t.me/Impfschaden_Corona_Schweiz/28651
Eine neue Meldung:
Hallo Mara
Wieder mal was neues aus dem Krankenhaus.
Eine Intensivpatientin aufgrund von Covid19. Das
Interessante: 4 Mal geimpft!!?? Impftouristin??
Wie kommt man an 4 Spritzen?
Die Abklärung wäre sehr wichtig, würde ja darauf
hindeuten, dass da einiges nicht zu funktionieren scheint.
Dass vieles nicht funktioniert, da bin ich überzeugt.
Patient, doppelt geimpft, während Operation diffuse
Blutung, kaum zu stillen. Weshalb haben wir
nicht rausgefunden. Aber es hat sicher NICHTS mit der
Impfung zu tun 🙈.
GENimpfschaden Blut nach GENimpfung Schweiz
6.11.2021: Verklebte Blutkörperchen und Gegenstände im
Blut
Impfschäden Schweiz Coronaimpfung, [06/11/2021 03:17 P.M.]
https://t.me/Impfschaden_Corona_Schweiz/28793
Diese Dunkelfeld-Bilder wurden am 28.09.2021 vom Blut eines
18 jährigen Mannes aufgenommen, der 10 Tage zuvor die erste
Dosis mit Biontech/Pfizer bekommen hatte. Sie zeigen
Anomalien, die die Untersuchende (Name ist Kanalbetreiberin
bekannt) laut ihrer Aussage in ihrer langen Zeit der Praxis
noch nie zuvor gesehen hat. Auch derjenige, der die Bilder
direkt vom Bildschirm abfotografiert hat, ist pers. bekannt.
GENimpfschaden: Blut
kaputt nach GENimpfung 6.11.2021: Die roten
Blutkiörperchen sind "gestapelt"
Impfschäden Schweiz Coronaimpfung, [06/11/2021 04:25 P.M.]
https://t.me/Impfschaden_Corona_Schweiz/28815
[Antwort auf Impfschäden Schweiz Coronaimpfung]
Eine Meldung dazu:
Liebe Mara, das Blutbild diesen 18jährigen ist wohl der
blanke Horror. Aber postet doch bitte ein gleiches
Blutbild eines gesunden Blutes…das dürfte das Ganze noch
eindrücklicher machen….diese Bilder könnten wir dann
weiter streuen eventuell ausdrucken und in altbewährter
Papierform in die Briefkästen verteilen.
Impfschäden Schweiz Coronaimpfung, [06/11/2021 04:30 P.M.]
https://t.me/Impfschaden_Corona_Schweiz/28819

Blut kaputt nach GENimpfung 6.11.2021: Die roten
Blutkiörperchen sind "gestapelt" [19]
Impfschäden Schweiz Coronaimpfung, [06/11/2021 04:30 P.M.]
https://t.me/Impfschaden_Corona_Schweiz/28820

Blut kaputt nach GENimpfung 6.11.2021: Die roten
Blutkörperchen sind "gestapelt" [20]
Medizinisches:
Blutbild unter dem Mikroskop 1800fach vergrössert
20.11.2021: GENimpfungen zerstören+verstopfen
Kapillaren
Impfschäden Schweiz Coronaimpfung, [20/11/2021 01:23
P.M.]
https://t.me/Impfschaden_Corona_Schweiz/31116
Rolands Beitrag: Ich habe ja das Blut (Blutbilder) von
den Leuten, die JETZT geimpft sind ... die Bilder von
vor der Impfung nun NACH der Impfung ... man sieht sehr
gut, wer nur ein Placebo bekiommen hat oder härteren
Stoff ... ich mache nun Studien mit den 2fach Geimpften,
und dann auch mit denen, ddie die dritte bekommen ...
man sieht, dass Stoffe in den Körper eingebracht werden,
die man so noch NIE gesehen hat, und die machen dann die
dünnsten Kapillaren und vieles mehr kaputt und
verstopfen das (das Blut wird im Zeiss-Mikroskop
auf 1 zu 1800 vergrössert). EINFACH NUR TRAURIG ... aber
wir stehen ja erst am Anfang

GENimpfschaden Kanton
Bern 24.11.2021: Frau (22) 2fach Pfizer GENgeimpft:
Erbrechen, Atemnot, Kraflosigkeit, Notfall,
Lungenembolie, Herzschaden, Blutschaden
Impfschäden Schweiz Coronaimpfung, [24/11/2021 07:27 P.M.]
https://t.me/Impfschaden_Corona_Schweiz/31727
Eine neue Meldung:
Liebe Mara! Erst einmal danke für Eure riesige, schon
lange dauernde, tolle Arbeit. Aus meinem Umfeld entschied
sich eine 22-jährige junge , total gesunde Frau nach
vielem Testen doch für die Impfung (Pfizer-B.) wenige Tage
nach der 2. Dosis heftiges Erbrechen, starke
Atembeschwerden, kaum Kraft zum Laufen- Notfall,
Lungenembolie, Herzprobleme, schlechte
Sauerstoffsättigung des Blutes - wurde mit
einem Attest für Freitag/ Samstag/Sonntag entlassen
(Kt. .Bern)🤔. Ich möchte, dass sie diese Folgen meldet,
Blutuntersuchung
in Sachsen 30.11.2021: Das volle Video 49min. mit
gesundem Blut und verklumptem Blut:
Der Test Teil 1/2 - Blutuntersuchung von Ungeimpften
& Geimpften mit erschreckenden Ergebnissen
Video-Link:
https://www.bitchute.com/video/eBUEUP0DbETw/
Gemeinsam mit einem Arzt und einem
Naturheilpraktiker haben wir am 29.11.2021 das Blut von
4 Ungeimpften und 4 Geimpften Personen
DER TEST TEIL 1/2 - BLUTUNTERSUCHUNG VON UNGEIMPFTEN
& GEIMPFTEN MIT ERSCHRECKENDEN ERGEBNISSEN
(49min.)
Video-Link:
https://www.bitchute.com/video/eBUEUP0DbETw/ -
Bitchute-Kanal: Brainstormy
- hochgeladen am
30.11.2021
Impfschäden Schweiz Coronaimpfung,
[02/12/2021 11:07 A.M.]
https://t.me/Impfschaden_Corona_Schweiz/32666
Eine neue Meldung:
Ein Arzt in Sachsen hat am Montag 29.11. in seiner
Praxis zusammen mit einem Naturheilpraktiker und dem
Kanalbetreiber von “Der Selbstdenker” eine vergleichende
Blutuntersuchung von jeweils 4 Geimpften und 4
Ungeimpften unter dem Dunkelmikroskop
durchgeführt. Jedes Detail wurde gefilmt, um Transparenz
und Glaubwürdigkeit zu demonstrieren.
Ergebnis: Die Struktur und Beweglichkeit der
Blutkörperchen weisen signifikante Unterschiede auf; so
sehr dass es einem schlecht wird.
Bei den Ungeimpften haben die Blutkörperchen eine runde
und abgegrenzte Struktur, die je nach Lebensweise
Unterschiede aufzeigt.
Bei den Geimpften mit Biontech und Moderna sieht man im
Dunkelmikroskop, wie die Blutkörperchen zu einem
Breiartigen Cluster zusammen gepappt sind und fast keine
Beweglichkeit mehr zeigen. Die Aufnahme von Sauerstoff
ist damit signifikant reduziert und wenn sich die
Blutkörperchen nicht mehr bewegen können, sind auch die
Aufgaben im Organismus nicht mehr möglich. Der Arzt sagt
im Video (lange Version), dass damit auf Dauer ein
Sauerstoffmangel in sämtlichen Organen zu erwarten ist.
Das die diese sichtbar unbeweglichen Verklumpungen im
Blut die Gefäße verstopfen können, ist für jeden logisch
denkenden Menschen klar erkennbar.
Zudem waren bei Geimpften Patienten auch merkwürdige
Verunreinigungen erkennbar wie Parasiten/Würmer und auch
“Glassplitter” bzw. feste Partikel. Alles Stoffe, die
keinesfalls in den Körper gehören.
Medizinisches Thema
Blut 30.11.2021: GENgeimpfte haben Blutzellen
aufgereiht ohne Bewegung:
https://www.wochenblick.at/schock-mikroskop-analyse-zeigt-voellig-verklumptes-blut-bei-geimpften/
Eine maßnahmenkritische Gruppe aus Sachsen hat
Blut von geimpften und impf-freien Personen unter einem
Dunkelfeldmikroskop untersucht. Was sie entdeckten,
schockiert: Extreme Verklumpungen bei den Geimpften sind
zu erkennen. Dies kann zu einer
Sauerstoffunterversorgung im Körper führen.
In einer Arztpraxis untersuchte die Gruppe am
29. November Blutproben von Geimpften und Impf-Freien.
Es wurde allerdings kein Blutbild gemacht, sondern die
Proben mit einem Dunkelfeldmikroskop untersucht.
Die vollständige Videoaufzeichnung des
Experimentes soll heute gegen 19 Uhr im Telegram-Kanal
„Der Selbstdenker“ online gestellt werden.
Hier wird nur das Blut der ersten beiden
Versuchspersonen, eine geimpft und eine nicht geimpft,
verglichen. Es wird im Video allerdings versichert, dass
die Ergebnisse durchwegs ähnlich waren und aufgerufen,
das Video möglichst weit zu verbreiten, um doch manche
zum Überlegen zu bringen, ob sie sich nach dem Video
immer noch impfen lassen wollen.
Schockiert über Ergebnis – wandten sich daher an Wochenblick
Die bei allen Versuchspersonen gleiche Vorgehensweise
gestaltete sich dabei folgend: Man hat das Blut mittels
kleiner Nadel abgenommen, auf einen Objektträger
aufgetragen und vor laufender Kamera im
Dunkelfeldmikroskop betrachtet. Das Blut von
vier geimpften und vier ungeimpften Personen wurde dabei
verglichen. Was unter dem Mikroskop zu sehen war,
schockierte die Gruppe dermaßen, dass sie sich für eine
schnellstmögliche Veröffentlichung sofort an den Wochenblick
wandte. In der Zuschrift heißt es: „Es ist
selbst für Laien sofort erkennbar, dass mit dem Blut
der geimpften Probanden irgendetwas nicht stimmt. Es
ist zum Aufwachen gedacht.“
Blut des Ungeimpften – wirkt „normal“
Als erstes wird ein Nicht-Geimpfter untersucht. Ein
klein wenig Blut wird vom Arzt abgenommen und sofort auf
einen Objektträger aufgebracht.

Ein Tropfen Blut des ersten Ungeimpften wird
abgenommen
Screenshot, Bildzitat

Danach folgt der Blick durch das Mikroskop: zu sehen
sind viele rote Blutkörperchen, manche davon
kleben zusammen. Das sei nicht ungewöhnlich,
kommentiert der Mediziner. Ein paar kleine
weiße Objekte sind zu sehen, die der Arzt als
„Schneegestöber“ bezeichnet und auf Elektrosmog
zurückführt.


Blutuntersuchung 04: normale Blutkörperchen wie
Billardkugeln
So sehen die roten
Blutkörperchen dieser ungeimpften Versuchsperson aus
Screenshot, Bildzitat
Als nächstes wird eine mit Moderna gespritzte Person
untersucht. Wieder das gleiche Vorgehen. Blutabnahme,
sofort auf den Objektträger und unters
Dunkelfeldmikroskop. Dieses liefert einen
schwarzen Hintergrund, wodurch Kontraste besser zu
erkennen sind.

Wieder die Blutabnahme. Diesmal bei einer Person, der
Moderna gespritzt wurde.
Screenshot, Bildzitat
Bei dieser Probe erschreckt man allerdings auch als
medizinischer Laie sofort, denn dieses Bild hat
mit dem vorherigen ohne Übertreibung nichts gemeinsam.
Konnte man beim ersten Probanden klar
umrissene, kreisrunde Strukturen, die roten
Blutkörperchen, wie erklärt wurde, erkennen, so ist auf
dem Bild des Moderna-Geimpften eine große,
zusammenhängende Struktur zu erkennen. Der
Arzt erklärt, dass es sich wieder um rote
Blutkörperchen handle, diesmal aber „verklumpt“ und in
„Cluster-Form“.

Blutuntersuchung 06: Verklumptes Blut einer GENgeimpften
Person
Wie der Arzt erklärt, führen diese
Verklumpungen der roten Blutkörperchen zu einem
herabgesetzten Sauerstofftransport im Körper.

Blutuntersuchung 06: Verklumptes Blut einer GENgeimpften
Person 02 [24]
Die Folge könne sein, dass die Organe
zu wenig mit Sauerstoff versorgt werden. Der
Mediziner hält auch fest, dass kein einziges
rotes Blutkörperchen zu erkennen ist.
Krankheiten, die dadurch ausgelöst werden können
Werden die Körperzellen nicht mit ausreichend
Sauerstoff versorgt, kann dies fatale Auswirkungen
haben. Hierzu wird auf Paracelsus.de festgehalten:
„Mittlerweile weiß man, daß eine
Sauerstoffunterversorgung (Hypoxie) und damit
verbundener Energiemangel im Organismus für mehrere
Krankheitsbilder mitverantwortlich ist, z.B.
- Migräne
- Durchblutungsstörungen in der Peripherie (z.B.
Beine)
- Durchblutungsstörungen im Gehirn und am Herzen
- Körperlicher und geistiger Leistungsabfall
- Abnahme der Konzentrations- und Merkfähigkeit
- Ohrensausen und Schwindel
- Abwehrschwäche (z.B. Anfälligkeiten für
Erkältungskrankheiten)“
Symptome einer Sauerstoff-Unterversorgung
Auf der Webseite GrossesBlutBild.de werden Symptome
beschrieben, die durch den Sauerstoffmangel
hervorgerufen werden: „Die Symptome eines Mangels an
Sauerstoff treten je nach Andauern des Zustands
in unterschiedlichen Stärken auf. Typisch
sind Schwindel- und Schwächegefühle, Müdigkeit
und allgemeines Unwohlsein. Zudem beschleunigt
sich der Puls und die Atmung verändert sich.
Betroffene leiden an Kurzatmigkeit und dem
Gefühl, nicht genügend Luft zu bekommen. Brustschmerzen
und körperliche Erschöpfung bei lediglich geringer
Anstrengung sind ebenfalls ein häufiges
Symptom zu Beginn des Zustands. (…)
Hält der Sauerstoffmangel längere Zeit an, kommen
Übelkeit, Zittern, Schweißausbrüche sowie abwechselnde
Hitze- und Kältegefühle hinzu. Die subjektive
Wahrnehmung der Umgebung verändert sich. Betroffene
fühlen sich leicht und ohne Anlass euphorisch. Einige
befinden sich in einem Delirium. Es kommt zu einer Schwächung
des gesamten Kreislaufs, die im schlimmsten Fall bis
hin zur Bewusstlosigkeit führt.“
3. GENimpfung 30.11.2021:
Die 3. GENimpfung ist wahrscheinlich kein Fake - Blut
unter dem Mikroskop kontrollieren
Impfschäden Schweiz Coronaimpfung, [30/11/2021 07:23 P.M.]
https://t.me/Impfschaden_Corona_Schweiz/32452
Eine neue Meldung:
Zahnärztin in Basel liess sich impfen - meine Warnungen
Hallo Mara,
heute war ich bei der Zahnärztin, wo ich alle halbe Jahre
zur Kontrolle gehe. Bis Mai 2021 habe ich von der
GENimpfung abgeraten, und im Mai 2021 sagte sie, ja sie
wolle diese möglichen Nebenwirkungen wirklich nicht. Heute
sagte sie mir, ja sie sei geimpft wegen Kundenkontakt.
Irgendwer hat sie also weichgeklopft, und die Helferinnen
scheinbar auch. Sie hat gemäss ihrer Aussage noch keine
Nebenwirkungen, aber ich warnte:
— die 3. GENimpfung wird dann sicher kein Fake mehr sein
— Fussballer starben vor 2019 2mal pro JAHR auf dem Feld,
heute 2mal pro MONAT
— sie solle ihr Blut unter dem Mikroskop untersuchen
lassen, ob das Blut noch gesund ist oder die Blutzellen
verchrugelet sind.
Nebenwirkung bei mir: Nach der Sitzung hatte ich wieder
ein Rumoren unter der Herzgegend beim Zwerchfell, jedes
starke Einatmen mit Bauch raus provozierte ein
gigantisches Erdbeben im linken Oberbauch - ist nun wieder
weg.
Gruss an alle und danke für eure Arbeit.
GENimpfschaden Altersheim Schweiz 1.12.2021:
Von 41 sind 36 wieder "positiv" - und es geht abwärts mit
ihnen, wenig Sauerstoff im Blut, extrem müde, z.T.
apathisch
Impfschäden Schweiz Coronaimpfung, [01/12/2021 09:32 P.M.]
https://t.me/Impfschaden_Corona_Schweiz/32613
Eine neue Meldung:
Hallo Mara,
Zu unseren mittlerweile 36 von 41 positiven Bewohnern. Am
19.11. wurden die ersten pos. getestet, das Ergebnis vom
durchtesten des ganzen Hauses haben wir seit 26.11.! Erst
seit 2-3 Tagen fangen die AZ verschlechterungen an, tiefe
Sauerstoffsättigung, extreme müdigkeit, teils apatheit neben
den gewöhnlichen Grippesymptomen. Hat das sonst noch jemand
bemerkt? Ich finde schon speziell dass es teils fast 2
Wochen später beginnt!
Antikörpertest bei Labor
Dr. Risch (Schweiz) 3.12.2021: Gespräch erwähnt: Blut
von GENgeimpften ist dunkel+dick
Impfschäden Schweiz Coronaimpfung, [03/12/2021 09:20 P.M.]
https://t.me/Impfschaden_Corona_Schweiz/32867
Eine neue Meldung:
Liebe Mara
Ich habe heute meinen Antikörpertest beim Labor Dr. Risch
durchgeführt. Der Empfang war mässig (du bist sicherlich
nicht geimpft), aber dennoch professionell. Ich war
erstaunt darüber, wieviel Blut sie mir genommen haben. Da
immer öfters darüber gesprochen wird, dass das Blut der
geimpften dunkel und dick ist, wollte ich
nachfragen ob das jemand in der Gruppe bestätigen kann?
GENimpfschaden Blutbild
3.12.2021: Gesundes Blut verglichen mit zerstörtem,
GENgeimpftem Blut: Der Lügen-Bundesrat Berset will das
dem Volk verheimlichen!
Impfschäden Schweiz Coronaimpfung, [03/12/2021 11:15 P.M.]
https://t.me/Impfschaden_Corona_Schweiz/32874
[Weitergeleitet aus Frag den Bundesrat]

GENimpfschaden Blutbild 3.12.2021: Gesundes Blut
verglichen mit zerstörtem, GENgeimpftem Blut: Der
Lügen-Bundesrat Berset will das dem Volk verheimlichen!
[43]
GENimpfschäden
Schweiz 11.12.2021: GENgeimpfte haben z.T. sehr
dunkles Blut
https://t.me/Impfschaden_Corona_Schweiz/33945
(Fortsetzung)
Was ich auch bestätigen kann ist wirklich die
Tatsache, das bei manchen 💉💉 geimpften das Blut bei
der BE sehr dunkel und unatürlich ist.
Medizinisches: Blutproben
von GENgeimpften 14.12.2021: Die Mitarbeiter im Labor
"sind sehr stumm" geworden
Impfschäden Schweiz Coronaimpfung, [14/12/2021 03:24 P.M.]
https://t.me/Impfschaden_Corona_Schweiz/34273
Eine neue Meldung:
Salü liebe Mara und Sina
Eine Frage in eure Gruppe.
Letzter Zeit fahre ich etwas mehr Blut Plättchen zu den
Spitälern.
Die Mitarbeiter im Labor und Spitälern sind seit Wochen
sehr „stumm“ geworden. Ich bekomme keine richtige
Antworten.
Nun, es hat sicher in der Gruppe jemand wo ausgestiegen
ist und kein Schweige Gelübde mehr hat.
Bitte, für was braucht es Blut Plättchen?
Liebe Grüsse und besten Dank.
GENimpfschaden
Schweiz 18.12.2021: Frau (ca.25, hilfsbereit)
GENgeimpft: Wesensveränderung, kalt und egoistisch -
im Bekanntenkreis sind GENgeimpfte mit: Blutgerinnungsstörung,
Venenprobleme (CVI), Herzinfarkte, Entzündungen, Krebs
Impfschäden Schweiz Coronaimpfung, [18/12/2021 10:11
A.M.]
https://t.me/Impfschaden_Corona_Schweiz/34689
Eine neue Meldung:
Meine Tochter ist eingebrochen und liess sich am
Mittwoch impfen. Sehr hilfsbereit und umsichtig. Jetzt
Kalt und in sich gekehrt.. Zunehmend, körperlich aber
keine Beschwerden... Ich habe sie immer informiert. Etc.
pp. Auch ihr Frust war sie Untragbar. Sie weinte
und bat mich um meinen Segen...
Ich sagte ich finde die Impfung Scheisse. Aber ich
verstehe sie in ihrem jungen Alter wo man im Moment und
nich für die Zukunft lebt.
Meine Angst ist imens dass ihr was geschieht, mein Frust
gegenüber unserer Politik wächst in ein Ausmass, dass
ich Angst habe meinen Verstand zu verlieren. Ich arbeite
selbst als Pflegefachfrau. Und kenne immer noch niemand
der gestorben ist an Corona. Aber viele die mit
Blutgerinnungsstörungen(BGS), CVI, Herzinfarkte aufgrund
BGS oder Entzündungen nach der Gentherapie. Aufblühende
Krebserkrankung. Die Menschen sehen die Zusammenhänge
nicht, sie wollen nicht. Ihre Weltanschauung, ihre
Fassade, ihre Rolle als Persona dann in Frage gestellt.
Verdammt nochmal! Die Menschen produzieren selber
Spikes. Und das Problem an Corona sind die Spikes... Und
jetzt die Kinder sollen zum Opferaltar geführt werden...
GENimpfschaden Schweiz
19.12.2021: GENgeimpfte mit Augenschäden: haben oft
geplatzte Äderchen in der Retina - Blut von GENgeimpfte
ist "schwarz" - Senkungsmessung ist nicht möglich
Impfschäden Schweiz Coronaimpfung, [19/12/2021 07:13 P.M.]
https://t.me/Impfschaden_Corona_Schweiz/34870
Eine neue Meldung:
Liebe Mara,
von einem Pat. erzählt: ein Kunde von ihm, Optiker,
erzählt, dass bei sehr vielen Gestochenen im
Augenhintergund, wenn er mit dem Binokular reinschaue,
Äderchen geplatzt seien (in der Retina).
Von einer Pat. erzählt, welche als MPA arbeitet: Das Blut
von vielen Gestochenen sei "schwarz" (bzw. dunkelrot). Vor
dem Beginn der Senkungsmessung stelle sie das Gläschen auf
den Kopf, um das Blut zu vermischen, das sich bereits ein
wenig gesenkt habe. Bei vielen Gestochenen sei es so, dass
das Blut sich nicht mische, nicht mal, von oben nach unten
rutsche.
Blut 23.12.2021: Blut von GENgemipften wird
in 3 Minuten steif
Video: https://t.me/MASKENFREI_ME/48633
Er nahm dieses Blut von einem geimpften Patienten ab und
bemerkte, dass sich der Fluss im zweiten Röhrchen deutlich
verlangsamt hatte.
Als er drei Minuten später in den hinteren Teil des Labors
kam, war dies das Ergebnis!
Normalerweise dauert es 30 Minuten, bis das Blut in einem
SST-Röhrchen gerinnt... nicht 3 Minuten.
Medizinisches:
Blutschaden bei GENgeimpften in Brasilien 11.1.2022:
Blut neigt zu Verdickung, Thrombosen, Herzinfarkte - das
GENgeimpfte Blut bleibt im Schlauch stecken -
DIMERO-D-Labortest zum Testen der Blutgerinnung
Das INTERNATIONALE ROTE KREUZ hat vor ein paar Wochen
erklärt, dass sie keine Blutspenden von geimpften Menschen
annehmen werden und das ist der Grund.
https://t.me/booomaktuell/18119
Das Blut der meisten geimpften Menschen verdickt sich und
gerinnt schnell, was eine der Hauptursachen für Thrombosen
und plötzliche Herzinfarkte ist.
Die Krankenschwester kann das Blut nicht einmal aus der
Frau herausholen, weil der Schlauch verstopft ist, weil es
zu zähflüssig ist.
Mit dem DIMERO D-Labortest erfährst du, ob dein Blut einen
hohen Grad an Gerinnung aufweist und kannst so schnell wie
möglich Hilfe suchen...!!!🧐
@rt_de
Medizinisches Blut spenden 17.1.2022:
Swissmedic Suchplattform meint: GENgeimpfte 48 Stunden
ohne Nebenwirkungen dürfen Blut spenden
Impfschäden Schweiz Coronaimpfung, [17/01/2022 08:49 A.M.]
https://t.me/Impfschaden_Corona_Schweiz/37470
hoi mara und team
zur frage ob geimpfte blut spenden dürfen...
eindeutig ja
Foto 1: https://t.me/Impfschaden_Corona_Schweiz/37471
Foto 2: https://t.me/Impfschaden_Corona_Schweiz/37472

Medizinisches Blut spenden 17.1.2022: Swissmedic
Suchplattform meint: GENgeimpfte 48 Stunden ohne
Nebenwirkungen dürfen Blut spenden Foto 1 [39]

Medizinisches Blut spenden 17.1.2022: Swissmedic
Suchplattform meint: GENgeimpfte 48 Stunden ohne
Nebenwirkungen dürfen Blut spenden Foto 2 [40]
Blut von GENgeimpften
Schweiz 18.1.2022: verfestigt sich in 30 Sekunden
Impfschäden Schweiz Coronaimpfung, [18/01/2022 05:48 P.M.]
https://t.me/Impfschaden_Corona_Schweiz/37601
[Antwort auf Impfschäden Schweiz Coronaimpfung]
Nachtrag: Das Blut gerinnt innert 30 Sekunden!
GENgeimpfte spenden Blut
in Muri (Kanton Aargau) 9.2.2022: auf volles Risiko
Impfschäden Schweiz Coronaimpfung, [09/02/2022 02:48 P.M.]
https://t.me/Impfschaden_Corona_Schweiz/39052
Eine neue Meldung:
Heute eine Kundin von mir (med. Massage) :
Mo-Morgen geboostert, Di-Nachmittag/Abend Blut gespendet!
Sie sagte: nach Dentalhygienik 7 Tage warten bis
Blutspende, nach Booster 48 Std. Das stand auf dem
Fragebogen vor dem Blutspende......!
Muri Aargau
GENgimpftes Blut
gespendet in der Schweiz 15.2.2022: wird NICHT
gekennzeichnet
Impfschäden Schweiz Coronaimpfung, [15/02/2022 07:27 P.M.]
https://t.me/Impfschaden_Corona_Schweiz/39441
[Antwort auf Impfschäden Schweiz Coronaimpfung]
Eine Meldung dazu:
Ich arbeite auf einer Intensivstation und verfolge das
Geschehen seit 15 Monaten sehr intensiv. Aus eigenem
Interesse, habe ich gestern beim zentralen
Blutspendedienst Schweiz einige Fragen gestellt, da
offiziell gilt, dass geimpfte Blut spenden dürfen. Meine
Fragen lauteten wie folgt:
1. Können auch geimpfte weiterhin Blutspenden?
2. Werden Blutkonserven entsprechend gekennzeichnet?
3. Wird sichergestellt, dass kein Blut von geimpften
verabreicht wird, wenn jemand dies nicht will?
4. Haftung bei Problemen; Vigilanz (Meldung von
unerwünschten Nebenwirkungen)?
Das rasch eintreffende Feedback lässt einen Standardbrief
vermuten, im wesentlich wird auf Swissmedic verwiesen
wird. Spannend im Feedback war jedoch der Satz ""Es ist
gesetzlich nicht vorgesehen, dass Blutprodukte von
geimpften Spendern besonders gekennzeichnet werden
müssen„. Dieser Satz beantwortet praktisch alle Fragen!
Es kann ganz normal weiterhin Blut gespendet werden, man
geht davon aus das dies kein Problem darstellt und nimmt
auch keine Rücksicht auf Personen welche kein
verunreinigtes Blut möchten. Die Haftungsfrage ist
ebenfalls obsolet da entsprechende Blutkonserven ohnehin
nicht gekennzeichnet werden.
Widerstand
in der Schweiz 22.3.2022: GENfreie Blutbank kommt: https://safeblood.ch/
Impfschäden Schweiz Coronaimpfung, [22.03.2022 08:28]
Spikefreie Blutbank in CH wird jetzt aufgebaut
https://t.me/Impfschaden_Corona_Schweiz/41140
Impfschäden Schweiz Coronaimpfung, [22.03.2022 08:28]
https://t.me/Impfschaden_Corona_Schweiz/41141
https://safeblood.ch/







![GENimpfschaden Blut von GENgeimpften Schweiz
9.9.2021: Blutspenden findet weiter OHNE Kontrolle
statt [20] GENimpfschaden Blut von GENgeimpften
Schweiz 9.9.2021: Blutspenden findet weiter OHNE
Kontrolle statt [20]](../../coronavirus/d/me119-ab-7sep2021-d/020-CH-blutspenden-ist-weiterhin-ohne-3G-zertifikat-9sep2021.jpg)